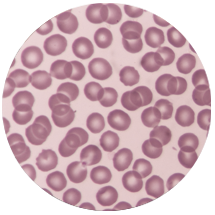

Effective results.
Shorter recovery times.
There are more options than ever when it comes to treating your musculoskeletal injury. Advancements in technology and research provide treatment options that are less invasive and require less recovery time.
Changing the way patients
approach treatment.
Leading-edge, minimally invasive procedures and regererative medicine treatment options provide you with solutions to your injuries that are safe and effective.

Minimally-Invasive
Procedures

Sports Medicine

Regenerative
Medicine

AN EVOLUTION IN TREATMENTS
AND PATIENT CARE.
Emerging technologies can provide new treatment options for patients, helping them to recover quicker and get them back to doing the things they love.
Non-surgical treatment options.
Emerging technology and treatment options provide patients with more options to treat many musculoskeletal injuries non-surgically.

Regenerative medicine treatment options.
Using your body’s own natural healing mechanisms to treat injuries.
A commitment to patient care.
Schedule a consultation with Dr. Hubbard to explore your treatment options today.
